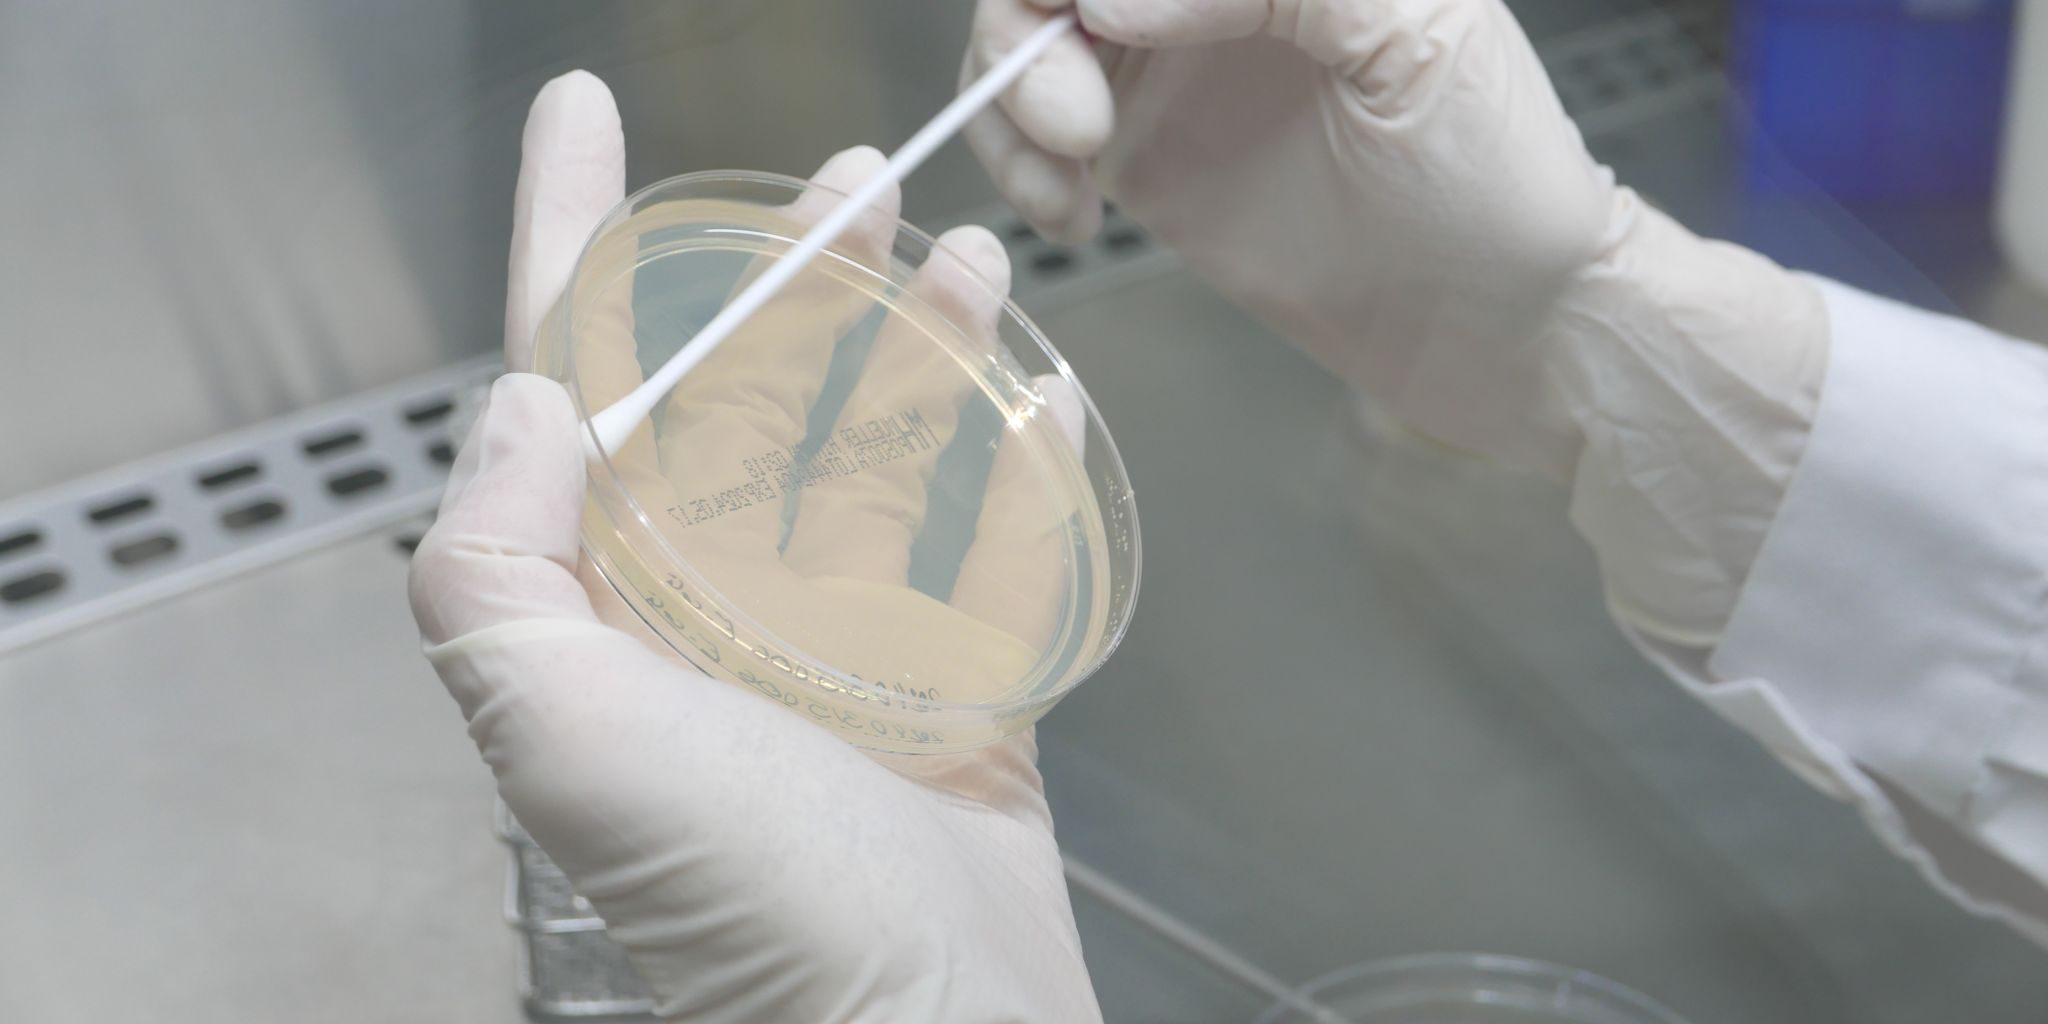
1721726233059

Realizar antibiogramas es una tarea diaria para nosotras y fundamental para el sector animal.
Procesamos las muestras recibidas y mediante esta técnica determinamos la susceptibilidad bacteriana y los antibióticos más efectivos para tratar cada caso.
Durante todo el proceso, seguimos estrictos protocolos de calidad y seguridad para garantizar la precisión de los resultados.
Desde Zenit proporcionamos información precisa y útil sobre los resultados de los antibiogramas, para ayudar en el diagnóstico y tratamiento de las infecciones en animales, manteniendo la más alta calidad en nuestro trabajo para contribuir a la salud y bienestar animal.